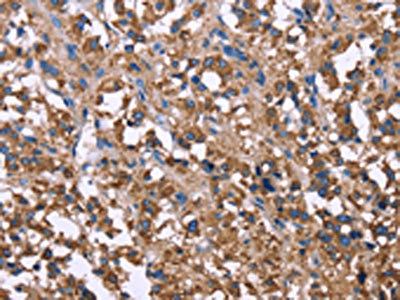
CSB-PA799490

SERPINA1
SERPINA1,即α1-抗胰蛋白酶,是一種主要在肝臟中合成的絲氨酸蛋白酶抑制劑。它是SERPIN家族成員之一,通過與胰蛋白酶等絲氨酸蛋白酶形成穩(wěn)定的復(fù)合物來抑制它們的活性。SERPINA1的作用機(jī)制是作為蛋白酶的底物,其活性位點(diǎn)的精氨酸殘基與蛋白酶的絲氨酸活性位點(diǎn)發(fā)生不可逆的共價(jià)結(jié)合,從而抑制蛋白酶的活性。這種抑制作用在防止組織損傷和炎癥反應(yīng)中發(fā)揮重要作用。SERPINA1在信號(hào)傳導(dǎo)中的作用涉及到多種生物學(xué)過程,包括抗炎、抗凝血和細(xì)胞凋亡等。在生物學(xué)意義上,SERPINA1對(duì)于維護(hù)肺健康尤其重要,其遺傳性缺乏可導(dǎo)致肺氣腫等呼吸系統(tǒng)疾病。此外,SERPINA1的多態(tài)性與多種疾病有關(guān),包括肝病和某些類型的癌癥。在臨床上,SERPINA1的活性水平可作為某些疾病的生物標(biāo)志物,用于疾病診斷和治療監(jiān)測(cè)。
熱銷產(chǎn)品
Recombinant Rat Alpha-1-antiproteinase (Serpina1) (CSB-EP021053RA)
驗(yàn)證數(shù)據(jù)

(Tris-Glycine gel) Discontinuous SDS-PAGE (reduced) with 5% enrichment gel and 15% separation gel.
SERPINA1 Antibody (CSB-PA799490)
驗(yàn)證數(shù)據(jù)
The image on the left is immunohistochemistry of paraffin-embedded Human thyroid cancer tissue using CSB-PA799490(SERPINA1 Antibody) at dilution 1/30, on the right is treated with synthetic peptide. (Original magnification: ×200)

The image on the left is immunohistochemistry of paraffin-embedded Human brain tissue using CSB-PA799490(SERPINA1 Antibody) at dilution 1/30, on the right is treated with synthetic peptide. (Original magnification: ×200)

Gel: 8%SDS-PAGE,Lysate: 40 μg,,Primary antibody: CSB-PA799490(SERPINA1 Antibody) at dilution 1/250 dilution,Secondary antibody: Goat anti rabbit IgG at 1/8000 dilution,Exposure time: 20 seconds
SERPINA1 Antibodies
SERPINA1 for Homo sapiens (Human)
| 產(chǎn)品貨號(hào) | 產(chǎn)品名稱 | 種屬反應(yīng)性 | 應(yīng)用類型 |
|---|---|---|---|
| CSB-PA021053GA01HU | SERPINA1 Antibody | Human,Mouse,Rat | ELISA,WB |
| CSB-PA004671 | SERPINA1 Antibody | Human | WB, ELISA |
| CSB-PA006124 | SERPINA1 Antibody | Human | WB, ELISA |
| CSB-PA213215 | SERPINA1 Antibody | Human | ELISA,IHC |
| CSB-PA213997 | SERPINA1 Antibody | Human | ELISA,IHC |
| CSB-PA799490 | SERPINA1 Antibody | Human | ELISA,WB,IHC |
| CSB-PA12565A0Rb | SERPINA1 Antibody | Human | ELISA |
| CSB-PA12565B0Rb | SERPINA1 Antibody, HRP conjugated | Human | ELISA |
| CSB-PA12565C0Rb | SERPINA1 Antibody, FITC conjugated | Human | |
| CSB-PA12565D0Rb | SERPINA1 Antibody, Biotin conjugated | Human | ELISA |
SERPINA1 for Rattus norvegicus (Rat)
| 產(chǎn)品貨號(hào) | 產(chǎn)品名稱 | 種屬反應(yīng)性 | 應(yīng)用類型 |
|---|---|---|---|
| CSB-PA021053HD01RA | Serpina1 Antibody, Biotin conjugated | Rat | ELISA |
| CSB-PA021053HA01RA | Serpina1 Antibody | Rat | ELISA |
SERPINA1 Proteins
SERPINA1 Proteins for Rattus norvegicus (Rat)
| 產(chǎn)品貨號(hào) | 產(chǎn)品名稱 | 來源 |
|---|---|---|
| CSB-YP021053RA | Recombinant Rat Alpha-1-antiproteinase (Serpina1) | Yeast |
| CSB-EP021053RA | Recombinant Rat Alpha-1-antiproteinase (Serpina1) | E.coli |
| CSB-BP021053RA CSB-MP021053RA CSB-EP021053RA-B |
Recombinant Rat Alpha-1-antiproteinase (Serpina1) | Baculovirus Mammalian cell In Vivo Biotinylation in E.coli |
SERPINA1 Proteins for Bos taurus (Bovine)
| 產(chǎn)品貨號(hào) | 產(chǎn)品名稱 | 來源 |
|---|---|---|
| CSB-YP021053BO CSB-EP021053BO CSB-BP021053BO CSB-MP021053BO CSB-EP021053BO-B |
Recombinant Bovine Alpha-1-antiproteinase (SERPINA1) | Yeast E.coli Baculovirus Mammalian cell In Vivo Biotinylation in E.coli |
SERPINA1 Proteins for Sus scrofa (Pig)
| 產(chǎn)品貨號(hào) | 產(chǎn)品名稱 | 來源 |
|---|---|---|
| CSB-YP021053PI CSB-EP021053PI CSB-BP021053PI CSB-MP021053PI CSB-EP021053PI-B |
Recombinant Pig Alpha-1-antitrypsin (SERPINA1) | Yeast E.coli Baculovirus Mammalian cell In Vivo Biotinylation in E.coli |
SERPINA1 Proteins for Papio anubis (Olive baboon)
| 產(chǎn)品貨號(hào) | 產(chǎn)品名稱 | 來源 |
|---|---|---|
| CSB-YP021053ERI CSB-EP021053ERI CSB-BP021053ERI CSB-MP021053ERI CSB-EP021053ERI-B |
Recombinant Papio anubis Alpha-1-antitrypsin (SERPINA1) | Yeast E.coli Baculovirus Mammalian cell In Vivo Biotinylation in E.coli |
SERPINA1 Proteins for Chlorocebus aethiops (Green monkey) (Cercopithecus aethiops)
| 產(chǎn)品貨號(hào) | 產(chǎn)品名稱 | 來源 |
|---|---|---|
| CSB-YP021053DSU CSB-EP021053DSU CSB-BP021053DSU CSB-MP021053DSU CSB-EP021053DSU-B |
Recombinant Chlorocebus aethiops Alpha-1-antitrypsin (SERPINA1) | Yeast E.coli Baculovirus Mammalian cell In Vivo Biotinylation in E.coli |
SERPINA1 Proteins for Mus caroli (Ryukyu mouse) (Ricefield mouse)
| 產(chǎn)品貨號(hào) | 產(chǎn)品名稱 | 來源 |
|---|---|---|
| CSB-YP328635MUU CSB-EP328635MUU CSB-BP328635MUU CSB-MP328635MUU CSB-EP328635MUU-B |
Recombinant Mus caroli Alpha-1-antiproteinase (Serpina1) | Yeast E.coli Baculovirus Mammalian cell In Vivo Biotinylation in E.coli |
SERPINA1 Proteins for Mus saxicola (Brown spiny mouse) (Rock-loving mouse)
| 產(chǎn)品貨號(hào) | 產(chǎn)品名稱 | 來源 |
|---|---|---|
| CSB-YP720553MKR CSB-EP720553MKR CSB-BP720553MKR CSB-MP720553MKR CSB-EP720553MKR-B |
Recombinant Mus saxicola Alpha-1-antiproteinase (Serpina1) | Yeast E.coli Baculovirus Mammalian cell In Vivo Biotinylation in E.coli |
SERPINA1 Proteins for Pongo abelii (Sumatran orangutan)
| 產(chǎn)品貨號(hào) | 產(chǎn)品名稱 | 來源 |
|---|---|---|
| CSB-YP732764PYX CSB-EP732764PYX CSB-BP732764PYX CSB-MP732764PYX CSB-EP732764PYX-B |
Recombinant Pongo abelii Alpha-1-antitrypsin (SERPINA1) | Yeast E.coli Baculovirus Mammalian cell In Vivo Biotinylation in E.coli |
SERPINA1 ELISA Kit
SERPINA1 ELISA Kit for Homo sapiens (Human)
| 產(chǎn)品貨號(hào) | 產(chǎn)品名稱 | 樣本類型 | 靈敏度 |
|---|---|---|---|
| CSB-E11719h | Human α1-Antitrypsin,α1-AT ELISA Kit | serum, plasma | 19.5 nIU/mL |
SERPINA1 ELISA Kit for Rattus norvegicus (Rat)
| 產(chǎn)品貨號(hào) | 產(chǎn)品名稱 | 樣本類型 | 靈敏度 |
|---|---|---|---|
| CSB-EL021053RA | Rat Alpha-1-antitrypsin(SERPINA1) ELISA kit | serum, plasma, tissue homogenates | 15.6 ng/mL |













